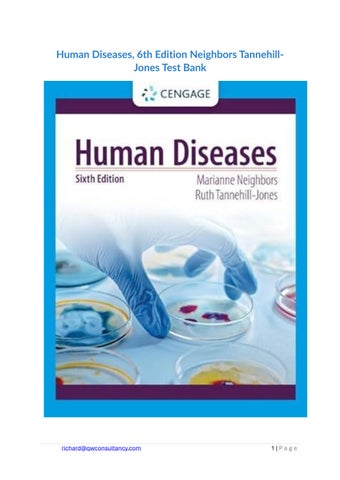

Advertisement

Share Public Profile
Ace Test Banks
We sell quality test banks and solutions manuals for all books, across all subjects. We guarantee full access to the resource immediately after purchase. No emails, no follow ups! If you need ANY specific test bank or solution manual, reach out using the channels below. We will provide a free chapter sample before purchase! Email (richard@qwconsultancy.com); WhatsAPP (+1 (564) 544-6478) for enquiries. Email (richard@qwconsultancy.com); WhatsAPP (+1 (564) 544-6478) for enquiries.